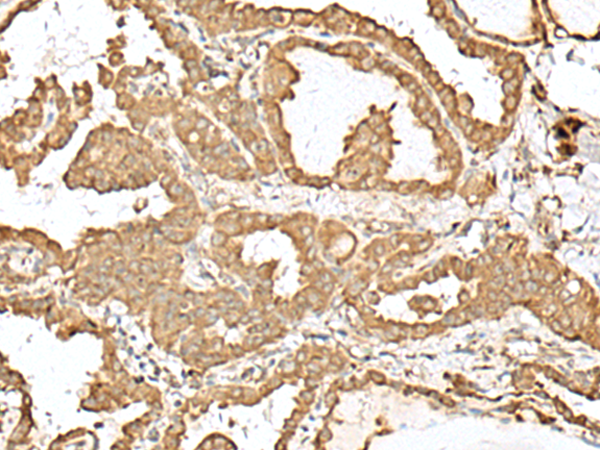

|
Background: |
The protein encoded by this gene is a catalytic subunit of the N-oligosaccharyltransferase (OST) complex, which functions in the endoplasmic reticulum to transfer glycan chains to asparagine residues of target proteins. A separate complex containing a similar catalytic subunit with an overlapping function also exists. Multiple transcript variants encoding different isoforms have been found for this gene. |
|
Applications: |
ELISA, WB, IHC |
|
Name of antibody: |
STT3A |
|
Immunogen: |
Fusion protein of human STT3A |
|
Full name: |
STT3A, catalytic subunit of the oligosaccharyltransferase complex |
|
Synonyms: |
TMC; ITM1; STT3-A |
|
SwissProt: |
P46977 |
|
ELISA Recommended dilution: |
5000-10000 |
|
IHC positive control: |
Human thyroid cancer |
|
IHC Recommend dilution: |
30-150 |
|
WB Predicted band size: |
81 kDa |
|
WB Positive control: |
Mouse liver tissue and Human placenta tissue lysates |
|
WB Recommended dilution: |
200-1000 |
購(gòu)物車(chē)
幫助
021-54845833/15800441009
